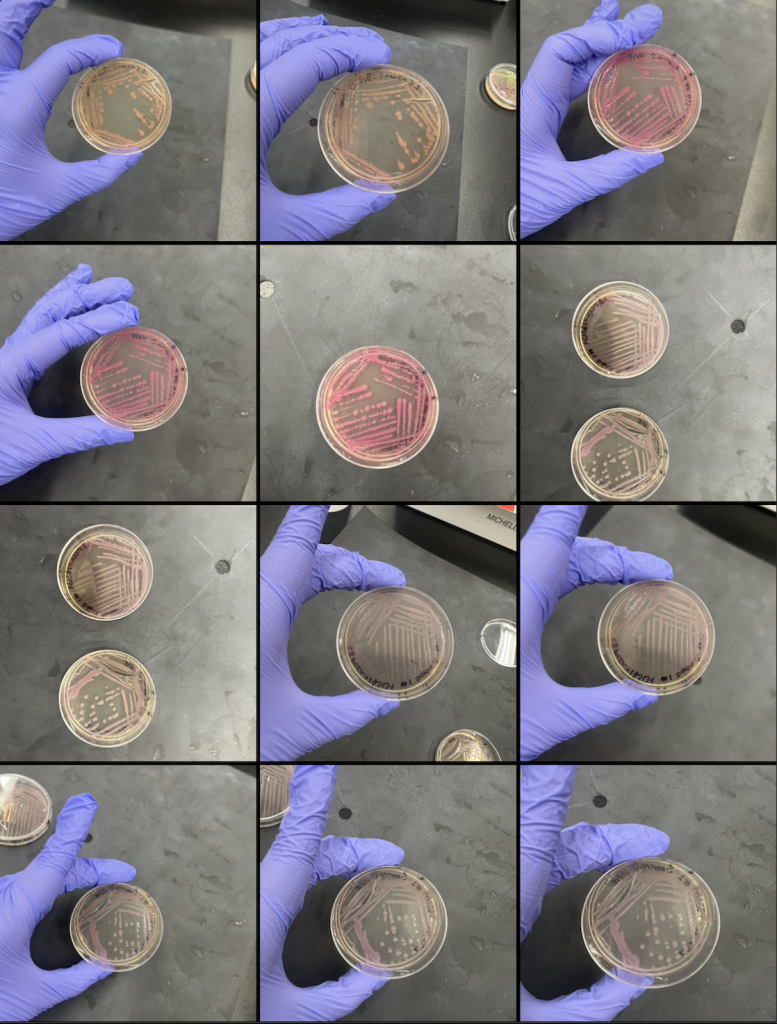
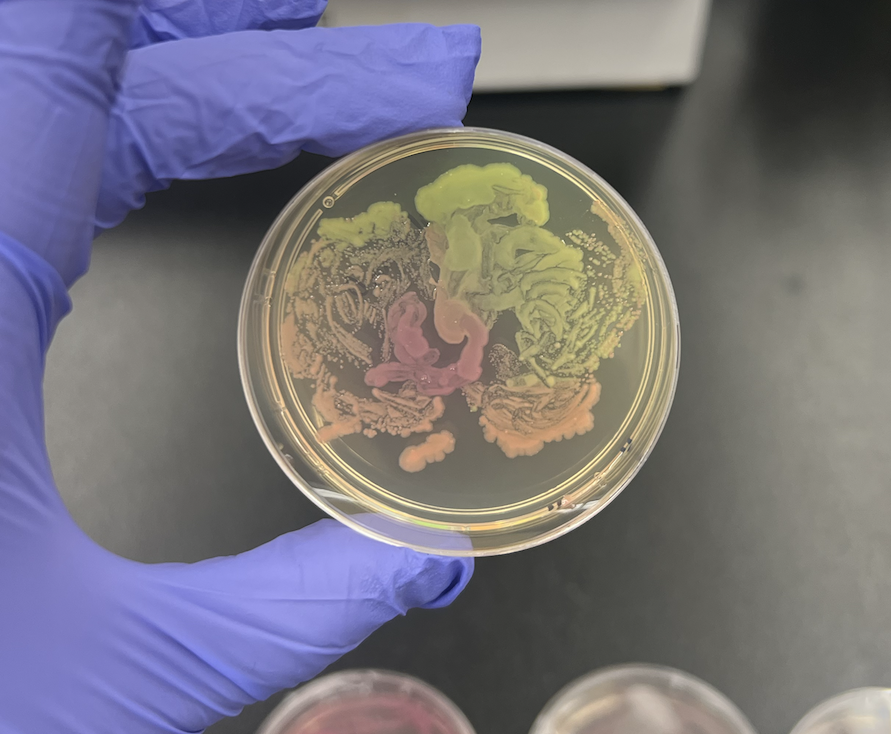
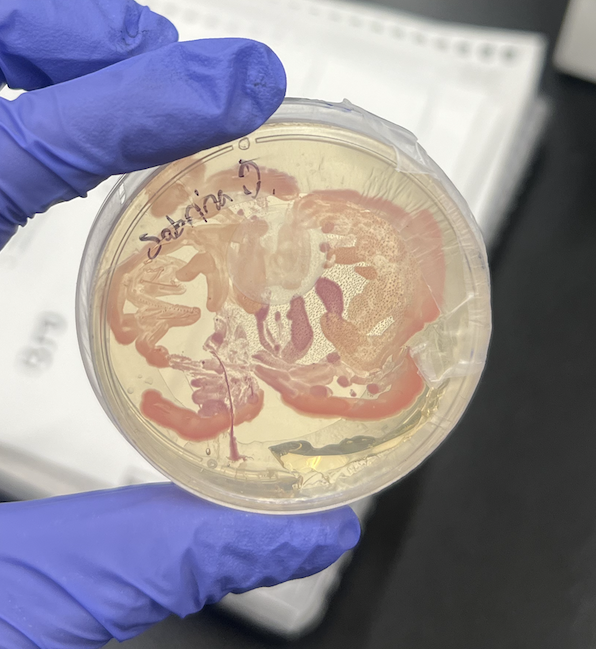

bacterial printing project
Project Overview
The most exciting thing to me during this first project in the lab was finding out that we had so many different shapes for all the plates to pour agar into. These “tiny, baby” ones were especially exciting to me and I knew immediately I wanted to use them despite not knowing what exactly I was doing with my project yet. Once I began pouring them and seeing all the plates lined up next to one another I liked the idea of having a layout similar where each individual plate can be sort of laid on top of one another in order to create one large canvas. When creating this larger canvas by plating the agar together to make one piece, it reminded me of a previous project I made by stitching small individual panels of cotton fabric to make a pillow which I cyanotyped family pictures onto. That piece, Mercado en Casa, was a nod to the fleeting of memories of my childhood and home as the pictures would fade away eventually over time. My bacterial cellulose project speaks to that, to the best of my ability I recreated one of these family pictures onto the poured agar. Using the genetically engineered bacteria we altered in the lab to draw the image, the image will only continue to grow over time, not fade. I can hold onto a distant memory a little bit longer.
Process
In order to create the larger canvas as mentioned I found it was best to run a toothpick across the edges of the agar inside the plate once it was set and then carefully scoop it out with the same toothpick and sort of pancake flip it into its final container. As for the image, I had printed a black and white version of the image I wished to draw onto the agar (this was the best way I could imagine to color block as obviously there are too many colors and details in a real life family portrait) and placed it underneath a glass container I wished to use as the final resting place for my piece. From there I just drew using the blue cell spreader and a toothpick.
my genetically engineered e coli
free hand drawing samples of orchids

agar “large” canvas to work on

final:

